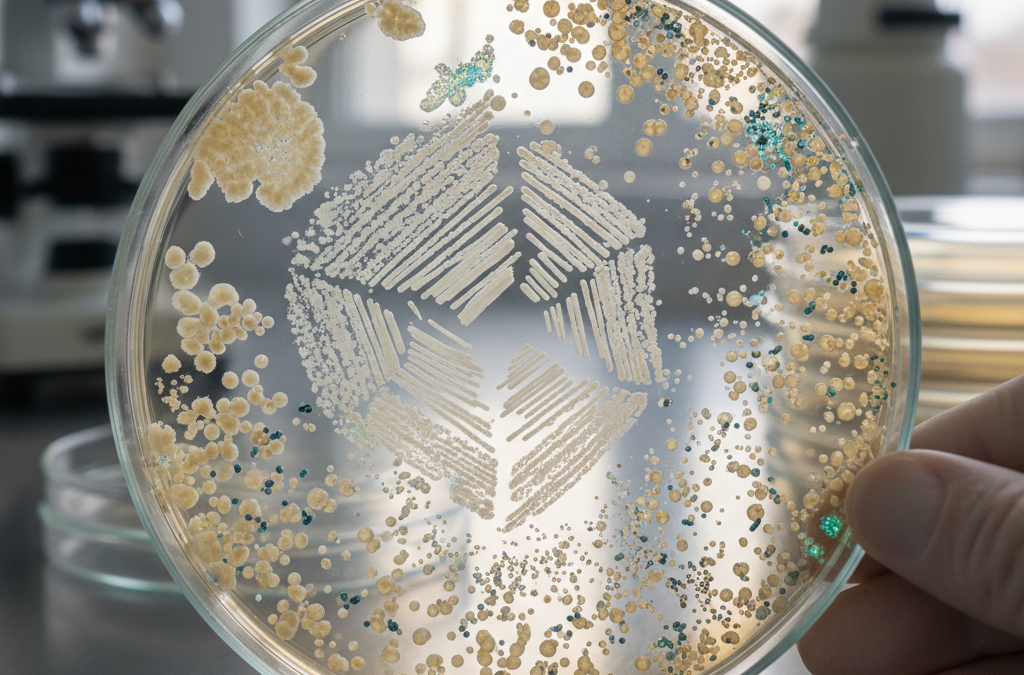

- Poród przedwczesny to główna przyczyna problemów zdrowotnych noworodków, a mikrobiom matki odgrywa w nim kluczową rolę.
- W pochwie zdrowej ciąży dominują Lactobacillus; ich spadek i wzrost bakterii beztlenowych zwiększa ryzyko porodu przedwczesnego.
- Zmiany w mikrobiomie jelitowym i jamy ustnej, w tym choroby przyzębia, sprzyjają stanom zapalnym prowadzącym do porodu przedwczesnego.
- Probiotyki mogą być obiecującą metodą interwencji, ale potrzebne są dalsze badania kliniczne.
Co to jest poród przedwczesny i dlaczego mikrobiom ma znaczenie?
Poród przedwczesny (PTB) pozostaje jedną z głównych przyczyn zachorowalności i śmiertelności noworodków na całym świecie. Stanowi poważne wyzwanie dla zdrowia matki i dziecka. Ostatnie postępy w badaniach podkreślają kluczową rolę mikrobiomu matki – obejmującego społeczności bakterii w pochwie, jelitach i jamie ustnej – w kształtowaniu wyników ciąży.
Zmiany w mikrobiomie pochwy podczas ciąży
W zdrowej ciąży mikrobiom pochwy jest zdominowany przez bakterie Lactobacillus, przy niskiej różnorodności mikrobiologicznej. Dysbioza, czyli zaburzenie równowagi, objawia się spadkiem liczby Lactobacillus i wzrostem bakterii beztlenowych. To zwiększa ryzyko porodu przedwczesnego.
Mikrobiom jelitowy a zdrowie ciąży
Mikrobiom jelitowy również ulega zmianom w trakcie ciąży. Obserwuje się zmniejszenie korzystnych bakterii i wzrost gatunków prozapalnych. Te przesunięcia wiążą się z niekorzystnymi wynikami ciąży, takimi jak poród przedwczesny.
Rola mikrobiomu jamy ustnej i chorób przyzębia
Zmiany w mikrobiomie jamy ustnej, zwłaszcza związane z chorobami przyzębia, mogą promować ogólnoustrojowy stan zapalny. To przyczynia się do porodu przedwczesnego. Infekcje zębowe, takie jak te wywołane przez Porphyromonas gingivalis, nasilają problem.
Mechanizmy, przez które mikrobiom wpływa na poród przedwczesny
Zaburzenia mikrobiomu mogą wyzwalać poród przedwczesny poprzez stan zapalny, zmiany immunologiczne i rozprzestrzenianie się mikroorganizmów do macicy. Te procesy prowadzą do przedwczesnego porodu. Mikrobiom ciąży jest potencjalnym biomarkerem i celem interwencji.
Probiotyki jako przyszłość prewencji
Terapie celujące w mikrobiom, takie jak probiotyki, wykazują obiecujące rezultaty. Mogą pomóc w przywróceniu równowagi bakteryjnej. Jednak potrzebne są dalsze badania kliniczne, aby potwierdzić ich skuteczność.
Autorzy i publikacja
Przegląd autorstwa Zhuojun Xie, Zhongsheng Chen i Guangyu Ma ukazał się w czasopiśmie Frontiers in Cellular and Infection Microbiology w 2025 roku (DOI: 10.3389/fcimb.2025.1683610). Autorzy deklarują brak konfliktu interesów. Słowa kluczowe: mikrobiom jelitowy, mikrobiom jamy ustnej, poród przedwczesny, probiotyki, mikrobiom pochwy.
Źródło: Oryginalny artykuł

Komentarze czytelników 0
Bądź pierwszą osobą, która podzieli się opinią!
Twoje doświadczenie może pomóc innym — napisz, co myślisz o tym temacie.
💬 Co sądzisz? Podziel się swoją opinią
Twój komentarz zostanie opublikowany po moderacji. Adres email nie będzie widoczny.